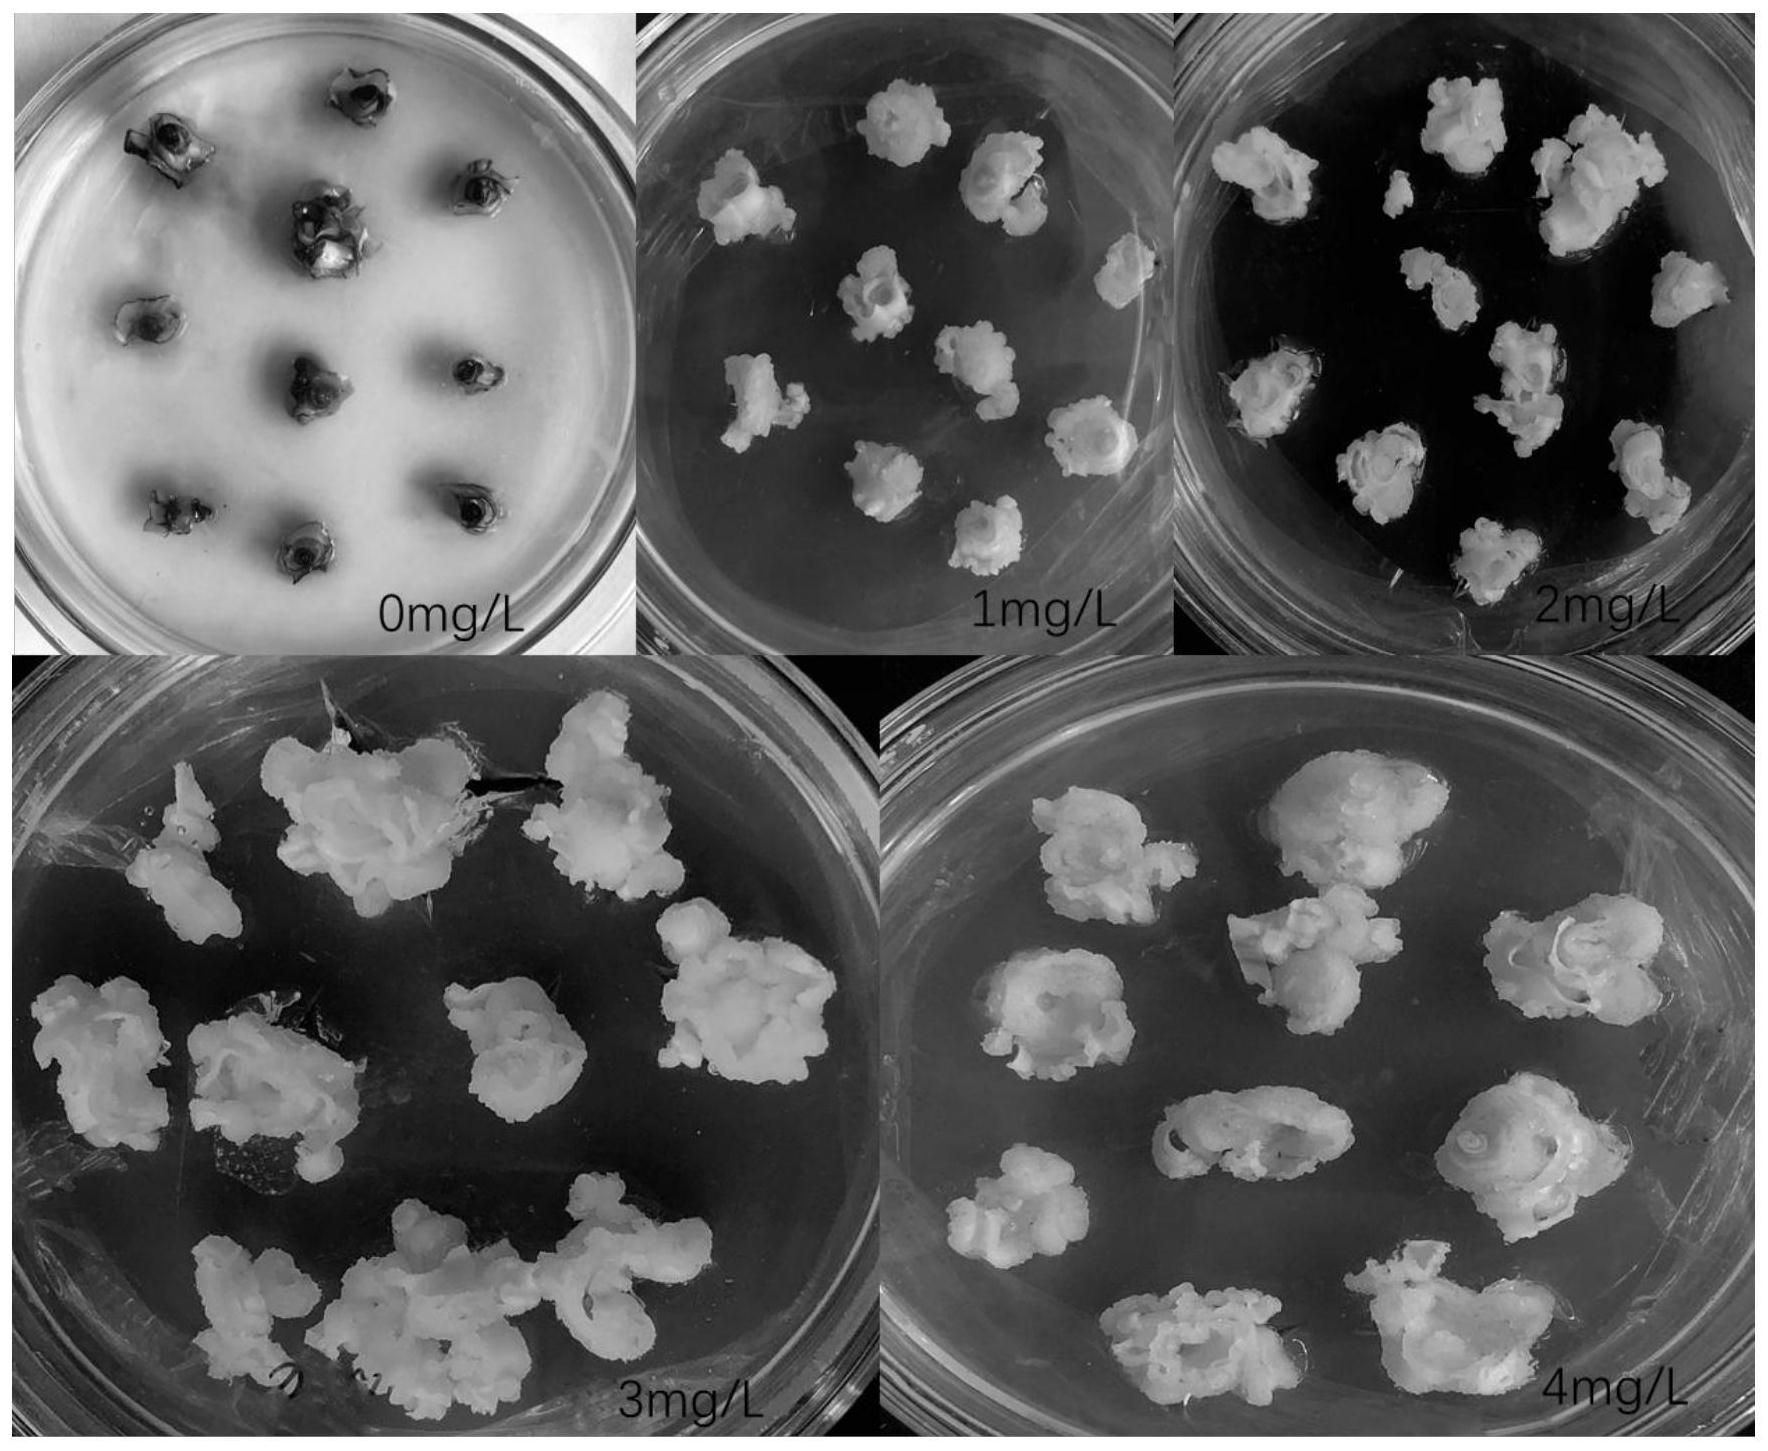
一种甘蔗品种胚性愈伤组织诱导方法

愈伤组织

增值后的愈伤组织
图片尺寸720x540
愈伤组织
图片尺寸2340x4160
水稻的愈伤组织
图片尺寸900x600
番茄转基因愈伤组织
图片尺寸506x900
菊花组织培养的愈伤组织细胞与枝条韧皮部细胞形态相同吗
图片尺寸864x648
不同分化阶段和类型的愈伤组织
图片尺寸4016x3741
愈伤组织类型与其显微结构
图片尺寸3747x2321
零距离看组培植物愈伤组织
图片尺寸1080x1920
海外直订callus culture 愈伤组织培养
图片尺寸800x800![氮素亏缺对苹果愈伤组织硝态氮吸收及同化的影响[j].](https://imgs.wantubizhi.com/img/A1A61BAA66193547F3A6DD7D8EE527E9935C32651EFA8954AF8DED6EE8F766142AD98D9D31A98935A51497893895645D9CFA506B9FB7B7FD2704531AC0ECEA2DB9BB9742C7CA89D2E55FBB2A307C6D77F42719E948820D2D12C87E3F189DA8E5)
氮素亏缺对苹果愈伤组织硝态氮吸收及同化的影响[j].
图片尺寸2756x3989
一种甘蔗品种胚性愈伤组织诱导方法
图片尺寸1768x1451
愈伤组织的培养及外植体的选择与培养
图片尺寸413x395
这样的愈伤组织能分化出芽吗
图片尺寸800x600
杂交枫香胚性愈伤组织遗传转化体系研究
图片尺寸3150x1707
籼稻中恢161胚性愈伤组织在不同质量浓度草甘膦培养基中培养20
图片尺寸3150x1443
伤口愈合过程皮肤外伤后愈合时,可见粉红色至鲜红色的颗粒状肉芽组织
图片尺寸956x637
吃一小勺植物的愈伤组织会怎么样?
图片尺寸844x570
愈伤组织的形成
图片尺寸1080x810
组培专题6愈伤组织的培养
图片尺寸1080x535
中药外用愈合外伤撕裂性伤口一例
图片尺寸2674x2000








![氮素亏缺对苹果愈伤组织硝态氮吸收及同化的影响[j].](https://imgs.wantubizhi.com/img/A1A61BAA66193547F3A6DD7D8EE527E9935C32651EFA8954AF8DED6EE8F766142AD98D9D31A98935A51497893895645D9CFA506B9FB7B7FD2704531AC0ECEA2DB9BB9742C7CA89D2E55FBB2A307C6D77F42719E948820D2D12C87E3F189DA8E5)















.png)
.png)


![氮素亏缺对苹果愈伤组织硝态氮吸收及同化的影响[j].](https://www.plantnutrifert.org/fileZWYYYFLXB/journal/article/zwyyyflxb/2019/11/PIC/18470-2_mini.jpg)